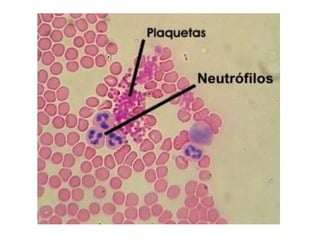

El sistema circulatorio transporta la sangre a través del cuerpo mediante las arterias, venas y capilares. La sangre transporta oxígeno, nutrientes y células inmunes a los tejidos y transporta dióxido de carbono y desechos lejos de los tejidos. El corazón bombea la sangre a través de dos circuitos, la circulación sistémica y la circulación pulmonar. Las enfermedades del sistema circulatorio incluyen la arteriosclerosis, la trombosis y el infarto de miocardio.